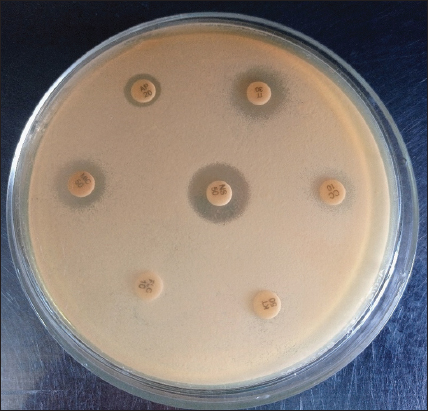

1. INTRODUCTION
Fungal infections, especially candidiasis caused by Candida, are one of the most common problems faced these days which require timely medical attention. The frequency of these infections increases furthermore due to the currently extended lifespan of the common population which includes the elderly and those who are immune compromised. Fungal infections may lead to fatal conditions such as fungemia and meningitis. Millions of people suffer from fungal infections annually [1-5].
Candida is the causative agent of the most common invasive fungal infection occurring in developed as well as developing countries. Diagnosis of candidiasis is usually delayed due to lengthy procedures like blood cultures which have low sensitivity. This is also because fungal-origin infections are suspected when the fever does not subside even after taking antibiotics [5,6]. There are around 30 species of Candida causing candidemia, but the most common among them are Candida albicans, Candida glabrata, Candida parapsilosis, and Candida tropicalis constituting 80% of the total Candidal infections [7,8]. Candida albicans is the most common opportunistic pathogen which is normally present in the oral cavity, conjunctiva, gastrointestinal, and genitourinary tracts. Invasive candidiasis caused due to Candida albicans amounts to 50–70% of total clinical cases. The four important antifungal drugs used at present times are azoles, polyenes, echinocandins, and pyrimidine analogs [9-11]. However, fatal prognosis if the pathogen is found to be resistant to one or more of the above antifungal agents. The problem gets further intensified as different Candidal species show diverse resistance patterns to various antifungal drugs. Hence, it is advisable to identify fungal strain, as well as have to perform the susceptibility test, to decide the appropriate choice of treatment [12-15]. Furthermore, one needs to consider the acquired resistance of the various species of Candida which is evolutionary leading to a lowering of susceptibility to a particular drug while treating an infection [13]. The above may be acquired by mutations and chromosomal rearrangements. Increasing resistant strains which include strains that are resistant to multiple drugs are now being reported all over the world through various studies [16-20].
The resistant phenotypes emerge during the period of the disease and also as a result of a particular treatment which can complicate the problem further [6,7]. As various factors (patients’ immune condition, virulence factors of candida) related to emergence of drug resistance of different types ofantifungal drugs, so, this study should be done from time to time to evaluate candida species involvement and drug susceptibility. Hence, our study aimed to evaluate antifungal resistance to different antifungals. It has also been seen that patients suffering from systemic diseases like diabetes show increased colonization of Candida. Other conditions such as neutropenia, malignancies treated with chemo/radiotherapy, or immunocompromised state arising due to long-term dose of steroid or antibiotics also show increased colonization of Candida [21-25].
This study was approved by the Institutional Ethical Committee (Ref. No. DMR/IMS.SH/SOA/180254), IMS and SUM Hospital, Siksha “O” Anusandhan University, Bhubaneswar. This study aimed to identify the antifungal susceptibility of Candida species isolates from the upper aerodigestive tract (oral and oropharyngeal) Candida infections.
2. MATERIALS AND METHODS
In this prospective study, all the patients attending to hospital for 2 years from January 2018 to Dec 2019 were included in the study. OPD patient who has local (poor oral hygiene, on inhaled steroid therapy, ill-fitting denture, and high sugar diet) or systemic predisposing factors (malnutrition, old age, iron deficiency, an endocrine disorder, on long-term antibiotics, or steroid therapy) for oral and oropharyngeal candidiasis were included in this study, whereas HIV patients were excluded in this study to confine the study to OPD group of patients. Three hundred samples were collected from the otorhinolaryngology department and dental department in a tertiary care teaching hospitals of Eastern India, Odisha.
Swab samples were collected from oral and oropharyngeal lesional area [Figure 1]. Collected samples were processed for fungal culture by inoculation in SDA (Sabouraud’s Dextrose Agar) medium. In an aerobic environment, plates were incubated at 37°C for 24 h after overnight incubation and colonies of Candida colonies were obtained. By use of Candida differential agar media, different colonies were identified on the basis of color (Light green color of Candida albicans, blue to purple color of C. tropicalis, cream to pinkish-white color of C. glabrata, fuzzy purple color of Candida krusei, and white to cream color of C. parapsilosis). With the use of various antifungal disk (Fluconazole (FLC10), nystatin (NS50), amphotericin B (AP20), itraconazole (IT30), ketoconazole (KT50), miconazole (MIC50), and clotrimazole (CC10) by disk-diffusion method, antifungal susceptibility test was carried out and inhibition zone was measured by following criteria of Hi-media, to know antifungal drug’s resistance and susceptibility [Figure 2].
 | Figure 1: Oral and oropharyngeal candidiasis. [Click here to view] |
| Figure 2: Antifungal susceptibility test by disk-diffusion method. [Click here to view] |
3. RESULTS
We have evaluated the Candida species and the drug’s susceptibility to identified Candida species, of upper aerodigestive (oral and oropharyngeal) fungal infections.
Out of 300 samples, 252 samples were positive for Candida infections. Further species identification on CDA agar done and found 137 samples as Candida albicans whereas 115 samples were non albicans candida species. The most prevalent species about 54.3% cases were Candida albicans, whereas 19% were C. tropicalis, 16.6% were C. glabrata, 6% were Candida krusei, and 4% cases were C. parapsilosis. The most abundant species among non-Candida albicans species was C. tropicalis. It has been also observed that Candida infections were seen more during September to December month may be due to the cold winter season one of the reasons for the occurrence of more infectious diseases and more use of higher antibiotic and weak immunity of individual can lead to candidiasis [Table 1]. Females’ patients showed more fungal infection with Candida albicans, C. tropicalis, C. glabrata, and Candida krusei as compared to the male patient [Table 2]. Regarding age group involvement ≥60 years age group of patients showed comparatively higher upper aerodigestive candidiasis infection (38.5%) in comparison to the adult age group (31.3%) [Table 3]. Figure 2 shows the disc diffusion method of the antifungal susceptibility test of a sample. Antifungal susceptibility test suggests that all Candida isolates species show the least resistance to itraconazole and amphotericin B whereas more resistant 60% to fluconazole by C. tropicalis than resistance to clotrimazole 54% by C. glabrata, resistance to nystatin 50% by Candida krusei, and resistance to ketoconazole 24% by C. tropicalis. C. parapsilosis showed 100% susceptibility to miconazole, itraconazole, and amphotericin B [Table 4].
Table 1: Timeline for Candida species (candida albicans and non-albicans) isolated from upper aerodigestive tract.
| Period of Sample collection | Candida albicans | Candida tropicalis | Candida glabrata | Candida. krusei | Candida parapsilosis |
|---|---|---|---|---|---|
| January–March 18 | 10 | 10 | 4 | 1 | 0 |
| April–June 18 | 12 | 8 | 03 | 0 | 0 |
| July–September 18 | 20 | 2 | 1 | 1 | 0 |
| October–December 18 | 22 | 4 | 12 | 2 | 0 |
| January–March 19 | 20 | 8 | 10 | 4 | 5 |
| April–June 19 | 12 | 10 | 6 | 7 | 3 |
| July–September 19 | 17 | 5 | 1 | 0 | 2 |
| October–November 19 | 16 | 1 | 2 | 0 | 0 |
| December 19 | 18 | 0 | 3 | 0 | 0 |
| Total=252 | 137 (54.36%) | 48 (19%) | 42 (16.6%) | 15 (5.9=6%) | 10 (3.9=4%) |
Table 2: Gender-wise distribution of Candida albicans and non-albicans species.
| Candida species | Male | Female | Total | % of candida species species |
|---|---|---|---|---|
| Candida albicans | 63 | 74 | 137 | 54.36 |
| Candida tropicalis | 21 | 27 | 48 | 19 |
| Candida glabrata | 19 | 23 | 42 | 16.6 |
| Candida. krusei | 7 | 8 | 15 | 6 |
| Candida parapsilosis | 6 | 4 | 10 | 4 |
Table 3: Occurrence of candida in different age group.
| Age groups | Male | Female | Total 252 |
|---|---|---|---|
| Children (0–18) | 35 | 41 | 76 (30.1%) |
| Adult (19–59) | 30 | 49 | 79 (31.3%) |
| Senior (old age ≥60) | 45 | 52 | 97 (38.5%) |
Table 4: Antifungal screening Profile of candida albicans and non-albicans species for all tested antifungal drugs.
| Antifungals Candida Sp. | Itraconazole IT30 | Ketoconazole KT50 | Amphotericin B AP20 | Nystatin NS50 | Fluconazole FLC10 | Clotrimazole CC10 | Miconazole MIC50 |
|---|---|---|---|---|---|---|---|
| C. albicans n=137 | 6.25% | 12% | 6.25% | 45% | 52% | 42% | 12% |
| C. tropicalis n=48 | 6.25% | 24% | 6.25% | 45% | 60% | 42% | 12% |
| C. glabrata n=42 | 6.25% | 6.25% | 6.25% | 45% | 52% | 54% | 6.25% |
| C. krusei n=15 | 6.25% | 12% | 6.25% | 50% | 38% | 42% | 6.25% |
| C. parapsilosis n=10 | 0 | 12% | 0 | 12% | 34% | 32% | 0 |
4. DISCUSSION
Candida species are found in the human body normally as human flora at various sites such as in the skin, oral cavity, gastrointestinal tract, and genital tract. However, under special circumstances like elderly patients, hospitalized and immunocompromised patients show growth of this opportunistic candida infection so there is the chance of invasive candidiasis in this group of patients. Proper laboratory setup is must otherwise led to false-positive results and most of the time, empiric antifungal therapy has become the choice of treatment in most patients having fever and septic infections or patients who have undergone surgeries with a venous catheter or under chemotherapy. One of the causes of rise in the resistant strains of fungi is due to undue usage of antifungal that further leads to delay in the treatment procedure for the patients. The treatment outcome of candidiasis is decided by various factors such as the immunity of the patient, severity of infection, and site of infection. The four important antifungal agents which are used these days are polyenes, azoles, echinocandins, and 5-Flucytosine. However, if antifungal resistance developed during treatment still poses a serious threat to the health of human populations [26-33].
In this study, the susceptibility in vitro of Candida strains was tested for amphotericin B, ketoconazole, clotrimazole, fluconazole, itraconazole, miconazole, and nystatin. The incidence of fungal infections has drastically increased over the past three decades and was simultaneously accompanied by increased acquired and innate resistance to antifungal drugs. However, epidemiological data regarding the incidence of resistance among fungal species are not identically distributed worldwide. According to most of the surveys done in the world, different susceptibility patterns of Candida species have been observed. C. glabrata and Candida krusei have been found to show low susceptibility to azoles whereas C. parapsilosis has low susceptibility to echinocandins. Minimum inhibitory concentration is designated as the lowest concentration of the tested compound, which is used to assess the level of susceptibility. Most laboratories nowadays do the disk-diffusion method in routine practice to analyze antifungal resistant of various candida species. The pattern of resistance shown by Candida in the globe is not a constant one as there is a rise in the resistant isolates constantly. It has been shown that the resistant species and increases after long-term use of a particular antifungal drug [31-36].
It has also been seen that the species resistant to a particular drug simultaneously develops resistance to other drugs leading to multidrug resistance (MDR). For example, C. glabrata and Candida krusei have low susceptibility toward azoles and develop resistance to echinocandins. Furthermore, the intensive use of antifungal in the past 15 years has led to an increase in MDR, especially in C. glabrata [7,22]. Hence, we have attempted to conduct a study to find out the susceptibility and resistance of the various Candida and non-Candida species to the various antifungal drugs commonly used in the Odisha population to see their results in the said population.
The most prevalent species was Candida albicans followed by C. tropicalis and the resistance of C. tropicalis isolated was highest for fluconazole and the lowest for itraconazole and amphotericin B which are in concordance with Clinical Practice Guideline for the Management of Candidiasis where suggested that fluconazole is less recommended [13,33]. As per the clinical experience of Santosh Kumar Swain [14] (ENT Specialist), itraconazole is more effective for treating upper aerodigestive fungal infections [34]. Amphotericin B is also effective, but its use should not be exceeded as it causes a nephrotoxicity effect. Although the first line of treatment of oropharyngeal candidiasis as topical (nystatin, clotrimazole, and amphotericin B oral suspension) and systemic oral azole (itraconazole, fluconazole, and posaconazole) [35,36] as increasing resistant of candida species toward fluconazole, so itraconazole should be advised. Herein, we reported resistance percentage to the various drugs such as itraconazole, amphotericin B, fluconazole, clotrimazole, miconazole, nystatin, and ketoconazole. The various Candida species vary in their susceptibility to the available antifungal agents. The intrinsic resistance to antifungal therapy observed in some species, along with the development of acquired resistance during treatment in others, is becoming a major problem in the management of Candida infections. Antifungal susceptibility testing has therefore become essential for effective patient management and resistance surveillance. Many studies carried out in the past have shown different drug resistance patterns for Candida [26,31-36].
Hence, we emphasize that a better understanding of the mechanisms and clinical impact of antifungal drug resistance is essential for the efficient treatment of patients with Candida infection and for improving treatment outcomes.
5. CONCLUSION
With this study, it is revealed that oral, oropharyngeal fungal infection shows variable resistance and susceptibility to antifungal. So before prescribing the antifungal, the clinician should advise for a culture susceptibility test so that the effective drug and right drug can be prescribed.
6. ACKNOWLEDGMENTS
We are grateful to Dr.(Prof) Neeta Mohanty, Dean, IDS, Bhubaneswar, for her encouragement to do research work and also thankful to Dr.(Prof) Sanghamitra Mishra, Dean, IMS and SUM Hospital Bhubaneswar for the extended facility in research at Medical Research Laboratory. This study article is a part of the PhD thesis of Dr Priyanka Debta in Dental Science, she is working as Professor at the Department of Oral Pathology and Microbiology, Institute of Dental Science, Siksha “O” Anusandhan Deemed to be University, Bhubaneswar. We are grateful to Dr.(Prof) Manoj Ranjan Nayak sir, Honorable President, Siksha “O” Anusandhan Deemed to be University, Bhubaneswar, for the academic facilities.
7. AUTHORS’ CONTRIBUTIONS
All authors made substantial contributions to conception and design, acquisition of data, or analysis and interpretation of data; took part in drafting the article or revising it critically for important intellectual content; agreed to submit to the current journal; gave final approval of the version to be published; and agreed to be accountable for all aspects of the work. All the authors are eligible to be an author as per the International Committee of Medical Journal Editors (ICMJE) requirements/guidelines.
8. FUNDING SOURCE
There is no funding to report.
9. CONFLICTS OF INTEREST
The authors report no financial or any other conflicts of interest in this work.
10. ETHICAL APPROVALS
This study was approved by the Institutional Ethical Committee (Ref. No. DMR/IMS.SH/SOA/180254), IMS and SUM Hospital, Siksha “O” Anusandhan University, Bhubaneswar.
11. DATA AVAILABILITY
All the data is available with the authors and shall be provided upon request.
12. PUBLISHER’S NOTE
This journal remains neutral with regard to jurisdictional claims in published institutional affiliation.
REFERENCES
1. Beck-Sague C, Jarvis WR. Secular trends in the epidemiology of nosocomial fungal infections in the United States, 1980-1990. National Nosocomial Infections Surveillance System. J Infect Dis 1993;167:1247-51. [CrossRef]
2. Fridkin SK, Jarvis WR. Epidemiology of nosocomial fungal infections. Clin Microbiol Rev 1996;9:499-511. [CrossRef]
3. Richards TS, Oliver BG, White TC. Micafungin activity against Candida albicans with diverse azole resistance phenotypes. J Antimicrob Chemother 2008;62:349-55. [CrossRef]
4. Rees JR, Pinner RW, Hajjeh RA, Brandt ME, Reingold AL. The epidemiological features of invasive mycotic infections in the San Francisco Bay area, 1992-1993:Results of population-based laboratory active surveillance. Clin Infect Dis 1998;27:1138-47. [CrossRef]
5. Wey SB, Mori M, Pfaller MD, Woolson RF, Wenzel RP. Hospital-acquired candidemia. The attributable mortality and excess length of stay. Arch Intern Med 1988;148:2642-5. [CrossRef]
6. Ksiezopolska E, Gabaldon T. Evolutionary emergence of drug resistance in Candida opportunistic pathogens. Genes (Basel) 2018;9:461. [CrossRef]
7. Arendrup MC, Patterson TF. Multidrug-resistant Candida:Epidemiology, molecular mechanisms, and treatment. J Infect Dis 2017;216 suppl 3:S445-51. [CrossRef]
8. Buschelman B, Jones RN, Pfaller MA, Koontz FP, Doern GV. Colony morphology of Candida spp. as a guide to species identification. Diagn Microbiol Infect Dis 1999;35:89-91. [CrossRef]
9. Arendrup MC. Epidemiology of invasive candidiasis. Curr Opin Crit Care 2010;16:445-52. [CrossRef]
10. Debta P, Swain SK, Sahu MC, Debta FM, Mohanty JN. A review on oral Candida as commensal and opportunistic pathogen. Indian J Forensic Med Toxicol 2020;14:8381-8.
11. Spampinato C, Leonardi D. Candida infections, causes, targets, and resistance mechanisms:Traditional and alternative antifungal agents. Biomed Res Int 2013;2013:204237. [CrossRef]
12. Magaldi S, Mata-Essayag S, de Capriles CH, Perez C, Colella MT, Olaizola C, et al. Well diffusion for antifungal susceptibility testing. Int J Infect Dis 2004;8:39-45. [CrossRef]
13. Rex JH, Rinaldi MG, Pfaller MA. Resistance of Candida species to fluconazole. Antimicrob Agents Chemother 1995;39:1-8. [CrossRef]
14. Swain SK, Debta P, Shajahan N. Primary fungal laryngitis:Our experiences at a tertiary care teaching hospital of Eastern India. Int J Health Allied Sci 2020;9:153-8. [CrossRef]
15. Redding S, Smith J, Farinacci G, Rinaldi M, Fothergill A, Rhine-Chalberg J, et al. Resistance of Candida albicans to fluconazole during treatment of oropharyngeal candidiasis in a patient with AIDS:Documentation by in vitro susceptibility testing and DNA subtype analysis. Clin Infect Dis 1994;18:240-2. [CrossRef]
16. Bennett JE, Izumikawa K, Marr KA. Mechanism of increased fluconazole resistance in Candida glabrataduring prophylaxis. Antimicrob Agents Chemother 2004;48:1773-7. [CrossRef]
17. Debta P, Swain SK, Mishra E Debta FM, Sarode G, Sahu MC. Antifungal stewardship“a pertinent exigency in mycobial treatment. Indian J Forensic Med Toxicol 2021;15:3813-20.
18. Eddouzi J, Parker JE, Vale-Silva LA, Coste A, Ischer F, Kelly S, et al. Molecular mechanisms of drug resistance in clinical Candida species isolated from Tunisian Hospitals. Antimicrob Agents Chemother 2013;57:3182-93. [CrossRef]
19. Costa LJ, Birman EG, Alves SH, Cury AE. Antifungal susceptibility of Candida albicans isolated from the oral mucosa of patients with cancer. Rev Odontol Univ Sao Paulo 1999;13:219-23. [CrossRef]
20. Vandeputte P, Ferrari S, Coste AT. Antifungal resistance and new strategies to control fungal infections. Int J Microbiol 2011;2012:713687. [CrossRef]
21. Arendrup MC. Candida and candidaemia. Susceptibility and epidemiology. Dan Med J 2013;60:B4698.
22. Chapeland-Leclerc F, Hennequin C, Papon N, Girard A, SociéG, Ribaud P, et al. Acquisition of flucytosine, azole, and caspofungin resistance in Candida glabrata bloodstream isolates serially obtained from a hematopoietic stem cell transplant recipient. Antimicrob Agents Chemother 2009;54:1360-2. [CrossRef]
23. Martin MV. The use of fluconazole and itraconazole in the treatment of Candida albicans infections:A review. J Antimicrob Chemother 1999;44:429-37. [CrossRef]
24. Krmek DZ, Nemet D. Systemic fungal infection in immunocompromised patients. Acta Med Croatica 2004;58:251-61.
25. Musial CE, Cockerill FR 3rd, Roberts GD. Fungal infections of the immunocompromised host:Clinical and laboratory aspects. Clin Microbiol Rev 1998;1:349-64. [CrossRef]
26. Perlin DS, Rautemaa-Richardson R, Alastruey-Izquierdo A. The global problem of antifungal resistance:Prevalence, mechanisms, and management. Lancet Infect Dis 2017;17:e383-92. [CrossRef]
27. Ghannoum MA, Rice LB. Antifungal agents:Mode of action, mechanisms of resistance, and correlation of these mechanisms with bacterial resistance. Clin Microbiol Rev 1999;12:501-17. [CrossRef]
28. Jensen RH. Resistance in human pathogenic yeasts and filamentous fungi:Prevalence, underlying molecular mechanisms and link to the use of antifungals in humans and the environment. Dan Med J 2016;63:B5288.
29. Meis JF, Verweij PE. Current management of fungal infections. Drugs 2001;61 suppl 1:13-25. [CrossRef]
30. Graybill JR, Vazquez J, Darouiche RO, Morhart R, Greenspan D, Tuazon C, et al. Randomized trial of itraconazole oral solution for oropharyngeal candidiasis in HIV/AIDS patients. Am J Med 1998;104:33-9. [CrossRef]
31. Akins RA. An update on antifungal targets and mechanisms of resistance in Candida albicans. Med Mycol 2005;43:285-318. [CrossRef]
32. Phillips P, Zemcov J, Mahmood W, Montaner JS, Craib K, Clarke AM. Itraconazole cyclodextrin solution for fluconazole-refractory oropharyngeal candidiasis in AIDS:Correlation of clinical response with in vitro susceptibility. AIDS 1996;10:1369-76. [CrossRef]
33. Saag MS, Fessel WJ, Kaufman CA, Merrill KW, Ward DJ, Moskovitz BL, et al. Treatment of fluconazole-refractory oropharyngeal candidiasis with itraconazole oral solution in HIV-positive patients. AIDS Res Hum Retroviruses 1999;15:1413-7. [CrossRef]
34. Farmakiotis D, Tarrand JJ, Kontoyiannis DP. Drug-resistant Candida glabrata infection in cancer patients. Emerg Infect Dis 2014;20:1833-40. [CrossRef]
35. Bhattacharya S, Sae-Tia S, Fries BC. Candidiasis and mechanisms of antifungal resistance. Antibiotics (Basel) 2020;9:312. [CrossRef]
36. Fichtenbaum CJ, Zackin R, Rajicic N, Powderly WG, Wheat LJ, Zingman BS. Amphotericin B oral suspension for fluconazole-refractory oral candidiasis in persons with HIV infection. Adult AIDS Clinical Trials Group Study Team 295. AIDS 2000;14:845-52. [CrossRef]